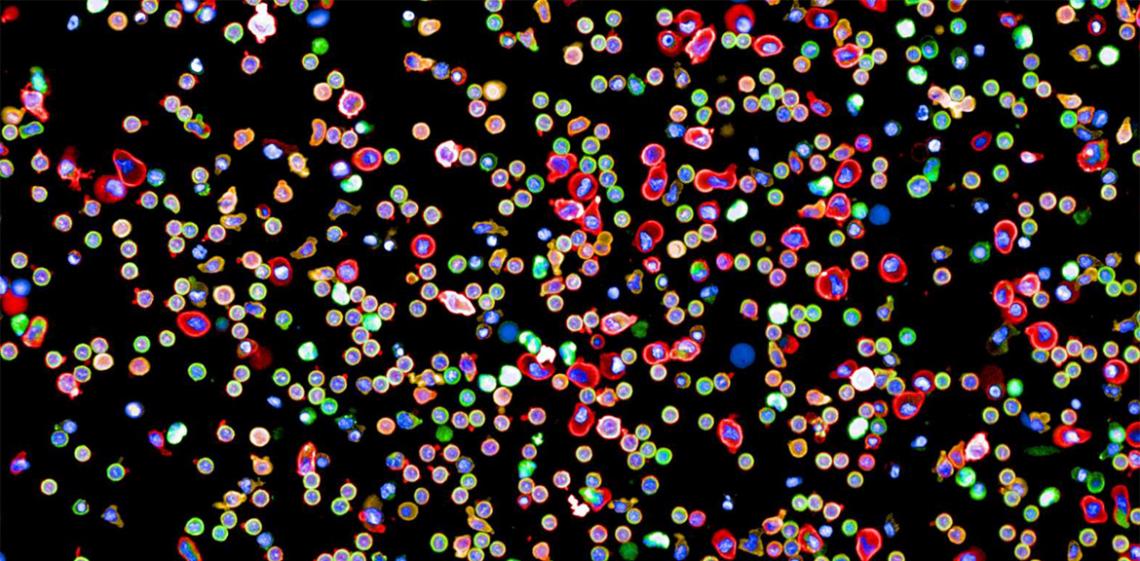

Image: Yannik Severin, Julien Mena, Berend Snijder / ETH Zürich
Researchers at ETH Zurich have created the first map of connection within the human immune system. The map shows how immune cells across the body link up and communicate to deal with threats.
Source: